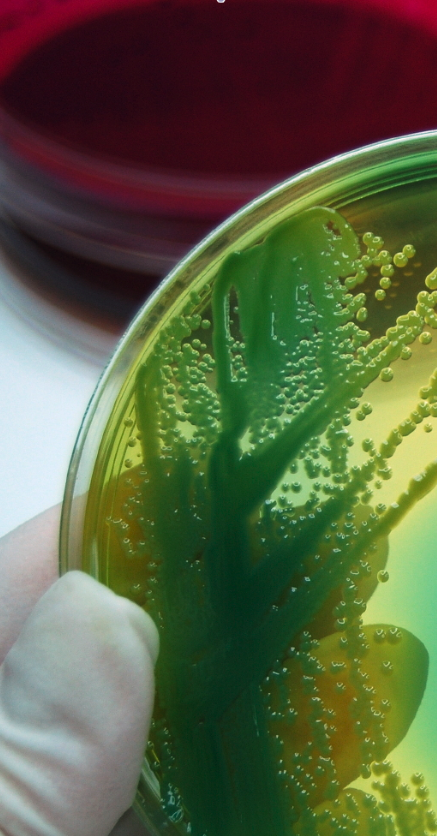
Life science sales strategies

There is a lot of funding and growth activity in academic markets across the country. If your company sells lab supplies, or equipment, or offers a researcher focused service, its a great market in which to increase your bottom line this year.
This week we are offering academic lab suppliers the opportunity to connect with well funded researchers at each of the markets that are highlighted in the blogs below with a series of special offers:
1) Your laboratory supply company can register to win a free exhibit space by entering your information in this form.
2) Your laboratory supply company can receive a complimentary premium upgrade when you let your sales rep know which of the following blogs you read and use the code Rogue 1
3) Can't attend the event in your selected market? For only $350 your company can include a printed product insert into the event bags distributed to all of the researchers attending the show (per show)
Recently published blogs:
- UC Davis receives $11.5M in Funding for Fragile X Research
- University of Massachusetts: $4M Grant for Plant Stem Cell Research
- Fred Hutch Event Raises $13M For Pediatric Cancer Research
- New Multidisciplinary Research Building in Progress at UC Riverside
- Thomas Jefferson Receives $3M for Research on Medicinal Cannabis
- WU Research: $34M to Build Better Maps of the Brain
- University of Southern California Opens a New Research Facility
- MSU Opens New $69.8 Million Bioengineering Research Facility
- Texas Medical Center Researchers Closer to Cause of Huntington's
- UGA Research: $1.3M Grant to Discover How Aberrant RNA Causes Disease